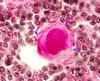

(02) Immune System I Flashcards
(22 cards)

megakaryocyte (bone marrow)
highlighted area

red cell nest (bone marrow)
highlighted area

granulocytic cell nest (bone marrow)

Erythroid cell nests (bone marrow)
the white blobs

adipocytes (bone marrow)
What tissue is this?

bone marrow
left of the yellow line

cortex (thymus)
right of the yellow line

medulla (thymus)
arrows

epithelial reticular cell (of cortex of thymus)
thymic corpuscle (thymus)
Identify the structure indicated by the blue arrows.

lymphoid nodule
Identify the area between the red arrows

dome (lymph nodule)
blue line

coricomedullary junction
bottom line

capsule (thymus)
red arrows

goblet cells (Peyer’s Patch)
blue box

lymphocytes
green arrows

M cells (Peyer’s patches)
Identify this tonsil

Palatine Tonsil (or oropharyngeal)
identify this tonsil

nasopharyngeal
yellow asterik

germinal center (lymph nodules)

Trabeculae (of thymus)
triangular arrow

mantle (corona) (of lymph nodules)